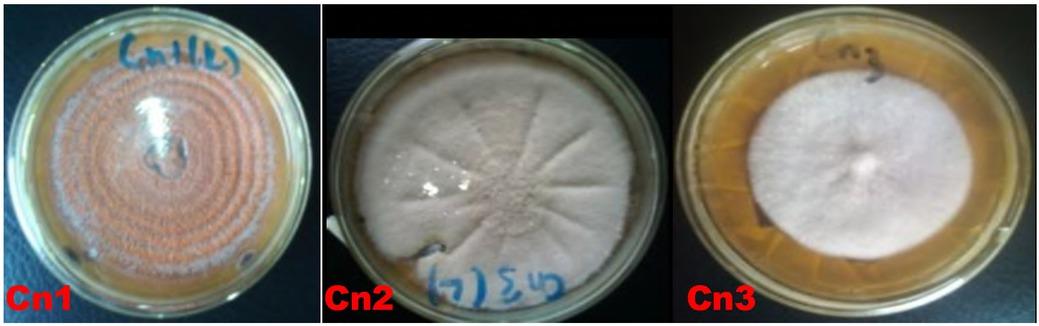

Figure 1
Figure 2

Figure 3

The antimicrobial activities of compounds detected in the fungal extracts
| Fungi Extract | Identified Compound | Reported Biological Activities |
|---|---|---|
| Cn1 | 4-hydroxyphenyl acetic acid | Antimicrobial (18, 19) |
| Indole-3-acetic acid | Antimicrobial (20, 21) | |
| Cn2 | P-hydroxybenzoic acid | Antimicrobial (22, 23) |
| Cn3 | Protocatechuic acid | Antimicrobial (23, 24, 25, 26) |
| P-hydroxybenzoic acid | Antimicrobial (22, 23) |
Cultural morphology and microscopic features of the endophytic fungi isolates from C_ nitida
| Isolates | Form | Elevation | Margin | Colour | Reverse | Growth Rate | Texture | Hyphae | Spores | Diameter (mm) | Suspected Organism |
|---|---|---|---|---|---|---|---|---|---|---|---|
| Cn1 | Circular | Flat | Curled | Orange | Light orange | Slow/moderate | Slimy and moist | Septed | Micro conidia | 75 | Acremonium (15) |
| Cn2 | Circular | Raised | lobate | White | Colourless with stripes | Moderate | Thick cottony and Dry | Septed | Micro conidia | 88 | Aspergillus II (16) |
| Cn3 | Circular | Nmbonate/Flat | Entire | white | Absent or pale brown-ish-yellow with age | Moderate | Cottony Smooth | Septed | Micro conidia | 60 | Trichophyton (17) |